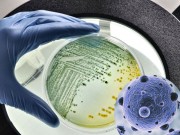
Nhà đẹp - Vệ sinh cặn bám vòi sen dễ dàng và hiệu quả

Ngay cả sau khi đã lau sạch, sàn nhà gạch vẫn bị những vệt đen trên vữa. Những mẹo dưới đây sẽ mang đến diện mạo mới cho căn nhà bằng những phương pháp tự nhiên với ít công sức nhất.
Cách 1: Làm sạch khe sàn gạch với baking Soda và Giấm
- Bước 1: Trộn đều 3 phần baking soda với 1 phần nước để tạo thành một hỗn hợp sền sệt. Hỗn hợp làm sạch đa năng này đánh bay các vết bẩn trên vữa, tuy nhiên không được dùng với những gia đình lát sàn bằng một số loại đá tự nhiên như đá cẩm thạch hoặc đá vôi.
- Bước 2: Bôi hỗn hợp sệt vừa trộn lên trên đường vữa bằng tay hoặc bàn chải đánh răng. Mặc dù baking soda và giấm không có hại nhưng bạn vẫn nên đeo găng tay cao su. Chúng có thể giúp ngăn ngừa các vết trầy xước có thể xảy ra khi vệ sinh nhà cửa, cũng như tránh da bị kích thích bởi vữa.
- Bước 3: Pha giấm trắng và nước theo tỉ lệ 1:1 vào trong bình xịt. Phun đều dọc theo đường vữa. Khi bạn nhìn thấy sủi bọt trên vữa là quá trình làm sạch tự nhiên đã bắt đầu.
- Bước 4: Phản ứng hóa học giữa baking soda và giấm sẽ sủi bọt trong vòng một vài phút. Sau khi bong bóng đã sủi hết là quá trình làm sạch bằng hóa chất đã kết thúc,
- Bước 5: Loại bỏ các vết bẩn còn sót lại bằng phương pháp vật lý. Dùng bàn chải đánh răng chà dọc theo các đường vữa. Chà kĩ hơn ở các góc và các cạnh tích tụ nhiều đất bẩn.
- Bước 6: Dùng giẻ ẩm lau sạch baking soda và giấm còn dư lại trên sàn. Bạn nên lau 2-3 lượt để tẩy sạch dư lượng chất tẩy tự nhiên còn trên sàn nhà.
Cách 2: Làm sạch khe sàn gạch với Oxy già, Baking Soda và Nước rửa bát
- Bước 1: Trộn 3/4 cốc baking soda, 1/4 cốc oxy già và 1 thìa nước rửa bát. Baking soda có tác dụng ăn mòn tự nhiên dùng để chà vữa, trong khi đó oxy già tạo ra phản ứng hóa học với baking soda để giải phóng ion tẩy trắng, còn nước rửa bát nới lỏng các vết bẩn và loại bỏ dầu mỡ.
Để kiểm tra xem hỗn hợp có ảnh hưởng đến màu sàn gạch hay không, bạn nên kiểm tra ở một góc khuất trước khi vệ sinh toàn bộ sàn nhà.
- Bước 2: Dùng bàn chải đánh răng bôi đều hỗn hợp lên các đường vữa giữa khe hai viene gạch.
- Bước 3: Hãy nguyên hỗn hợp trong 15 phút. Bạn có thể thấy phản ứng sủi bọt khi baking soda và oxy già tác dụng với nhau.
- Bước 4: Dùng giẻ mềm và nước ấm để lau sạch lại sàn nhà. Bạn nên cẩn thận khi di chuyển vì sàn lát gạch có thể rất trơn.